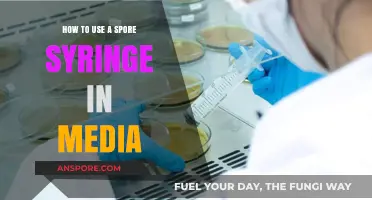
Mastering Spore Syringe Techniques for Effective Media Inoculation

Updating your graphics card drivers is essential for optimizing the performance of *Spore*, ensuring smoother gameplay and enhanced visuals. Outdated or incompatible drivers can lead to crashes, glitches, or poor frame rates, so it’s crucial to regularly check for updates. To update your graphics card, first identify your GPU model (NVIDIA, AMD, or Intel) through your device manager or system information. Visit the official website of your GPU manufacturer, download the latest driver compatible with your operating system, and follow the installation instructions. After installation, restart your computer and verify the update in the device manager. Additionally, enabling automatic driver updates can save time and keep your system running efficiently for an uninterrupted *Spore* experience.
| Characteristics | Values |
|---|---|
| Game | Spore |
| Platform | PC (Windows) |
| Graphics Card Update Method | Update GPU drivers |
| Driver Sources | NVIDIA GeForce Experience, AMD Radeon Software, Intel Driver & Support Assistant |
| Steps to Update Drivers | 1. Identify GPU model 2. Download latest driver from official site 3. Install driver 4. Restart PC |
| Alternative Method | Use Device Manager in Windows to update drivers |
| System Requirements Check | Ensure GPU meets minimum requirements for Spore |
| Common Issues | Outdated drivers, incompatible GPU, insufficient VRAM |
| Troubleshooting | Roll back drivers, check DirectX version, verify game files integrity |
| Latest Driver Versions (as of 2023) | NVIDIA: 500+ series, AMD: Adrenalin 23.X.X, Intel: 30.0.101.X+ |
| Official Support | EA Help, NVIDIA/AMD/Intel support forums |
What You'll Learn
- Check Compatibility: Ensure your graphics card meets Spore's minimum requirements for optimal performance
- Download Drivers: Visit the manufacturer's website to download the latest graphics card drivers
- Install Updates: Follow on-screen instructions to install the updated graphics card drivers correctly
- Verify Changes: Restart Spore to confirm if the graphics card update has improved visuals
- Troubleshoot Issues: Resolve common problems like crashes or glitches post-update with quick fixes

Check Compatibility: Ensure your graphics card meets Spore's minimum requirements for optimal performance
Before diving into updating your graphics card for *Spore*, it’s critical to verify whether your current hardware meets the game’s minimum requirements. *Spore* demands a DirectX 9.0c-compatible graphics card with at least 128 MB of video RAM, such as an NVIDIA GeForce 5600 or ATI Radeon 9600. If your card falls short, no amount of driver updates or tweaks will deliver optimal performance. Start by accessing your system’s Device Manager (on Windows) or System Information (on macOS) to identify your graphics card model. Cross-reference this with *Spore*’s official specifications to avoid unnecessary troubleshooting.
Analyzing compatibility isn’t just about meeting the bare minimum—it’s about understanding how your hardware limitations might impact gameplay. For instance, integrated graphics cards, like Intel HD Graphics, often struggle with *Spore*’s complex simulations, leading to frame rate drops or graphical glitches. If your card is borderline compatible, consider testing the game in its lowest settings to gauge performance. Tools like MSI Afterburner or FRAPS can monitor frame rates during gameplay, providing concrete data to assess whether an upgrade is necessary.
Persuasively, checking compatibility upfront saves time and frustration. Attempting to update drivers or modify settings on an incompatible card is akin to polishing a rusty tool—it won’t fix the core issue. Instead, use this step as a decision point: if your card is outdated, allocate resources toward an upgrade rather than temporary fixes. For example, a budget-friendly NVIDIA GTX 1050 or AMD RX 560 can significantly enhance *Spore*’s performance without breaking the bank.
Comparatively, modern games often have more lenient requirements, but *Spore*’s unique procedural generation and physics-based mechanics place specific demands on hardware. Unlike *Minecraft*, which runs smoothly on most integrated GPUs, *Spore*’s dynamic ecosystems and creature animations require dedicated video memory and processing power. By ensuring compatibility, you’re not just playing the game—you’re experiencing it as intended, with seamless transitions between stages and crisp visuals.
Descriptively, imagine *Spore*’s cell stage, where every movement ripples through the water, or the space stage, where galaxies sprawl across the screen. These moments require a graphics card that can handle vertex shading and texture rendering efficiently. If your card is incompatible, these scenes may appear choppy or distorted, detracting from the immersive experience. By prioritizing compatibility, you’re safeguarding the game’s artistic and technical achievements, ensuring every stage feels as alive and responsive as Maxis designed it to be.
Can Spores Legally Be Mailed to Nevada? Regulations Explained
You may want to see also

Download Drivers: Visit the manufacturer's website to download the latest graphics card drivers
Outdated graphics card drivers can bottleneck your gaming experience, especially for visually demanding titles like *Spore*. Manufacturers regularly release driver updates to optimize performance, fix bugs, and add compatibility for new games. By visiting your graphics card manufacturer’s website, you gain direct access to the latest drivers tailored for your specific hardware, bypassing the delays and inaccuracies of third-party updater tools.
The process begins with identifying your graphics card model. For NVIDIA users, open the GeForce Experience app or check Device Manager on Windows. AMD users can find this information via the Radeon Software or Device Manager as well. Once identified, navigate to the official website—NVIDIA, AMD, or Intel—and locate the driver download section. Use the search function or filter by product series to find the correct driver for your operating system (Windows 10, 11, etc.) and card model. Download the executable file, ensuring it matches your system’s bit version (32-bit or 64-bit).
Installation requires administrative privileges, so run the installer as an administrator. Follow the on-screen instructions, opting for a clean installation if prompted. This removes older driver remnants, reducing conflicts. After installation, restart your computer to apply changes. Verify the update by checking the driver version in Device Manager or the manufacturer’s software. For *Spore*, this step ensures the game leverages the latest optimizations, potentially improving frame rates and reducing graphical glitches.
While manufacturer websites are the gold standard, exercise caution with ads or misleading download buttons. Stick to the official download links, often highlighted or placed prominently on the page. Avoid third-party sites offering “driver packs” or automatic updaters, as these may bundle bloatware or outdated files. Regularly checking for updates, especially before playing graphically intensive games, keeps your system running smoothly and extends the lifespan of older hardware like that required for *Spore*.
Clear Spore's Graphics Cache: A Step-by-Step Guide to Free Up Space
You may want to see also

Install Updates: Follow on-screen instructions to install the updated graphics card drivers correctly
Updating your graphics card drivers is a critical step in ensuring that *Spore* runs smoothly, leveraging the full potential of your hardware. Once you’ve downloaded the correct driver update, the installation process is straightforward but requires attention to detail. Most driver installers are designed to guide you through the process with on-screen prompts, eliminating much of the guesswork. However, the key lies in following these instructions precisely to avoid errors that could disrupt your system or game performance.
The installation typically begins with a double-click on the downloaded file, which launches a setup wizard. This wizard will often present you with options such as *Express Installation* or *Custom Installation*. While the express option is faster and recommended for most users, the custom route allows you to deselect unnecessary components or tweak settings. For *Spore*, the express method usually suffices, as the game primarily benefits from core driver updates rather than additional utilities. Always ensure your system meets the minimum requirements for the driver version you’re installing, as compatibility issues can arise otherwise.
During installation, you may encounter prompts to restart your computer. This step is crucial, as it finalizes the driver update by loading the new software into your system’s memory. Ignoring or postponing the restart can leave your graphics card operating on outdated or partially installed drivers, potentially causing *Spore* to crash or display graphical glitches. If you’re in the middle of a task, save your work and close all applications before proceeding, as the restart is non-negotiable for successful installation.
One common pitfall is interrupting the installation process. Whether it’s closing the installer prematurely or shutting down your computer mid-update, such actions can corrupt the driver files, forcing you to start over. To avoid this, allocate a few uninterrupted minutes for the installation and ensure your system is connected to a stable power source if you’re using a laptop. Patience is key—rushing through the process can undo the benefits of updating your drivers in the first place.
After the installation and restart, verify that the update was successful. Open your device manager (accessible by right-clicking the Start menu and selecting *Device Manager*) and locate your graphics card under *Display adapters*. The driver version should reflect the update you just installed. If *Spore* still exhibits performance issues, consider checking for additional updates or troubleshooting hardware conflicts. Properly installed drivers not only enhance gameplay but also contribute to the overall stability of your system, making this step a worthwhile investment of your time.
Could Voyager's Tech Harness the Power of a Spore Drive?
You may want to see also

Verify Changes: Restart Spore to confirm if the graphics card update has improved visuals
After updating your graphics card drivers or settings to enhance Spore’s visuals, the final step is to verify whether the changes have taken effect. Restarting the game is the most straightforward way to confirm improvements, but it’s not just about launching Spore again. Pay close attention to specific visual elements like texture sharpness, lighting effects, shadow detail, and frame rate stability. These are the areas most likely to show noticeable upgrades after a graphics card update. For instance, if you’ve switched from integrated to dedicated GPU settings, look for smoother animations during creature movements or more vibrant colors in the space stage.
To maximize the verification process, compare the game’s performance before and after the update. If possible, use in-game benchmarks or record gameplay snippets for side-by-side analysis. Note any reductions in screen tearing, improved anti-aliasing, or enhanced water reflections in aquatic environments. If you’ve updated to a newer graphics driver, check for features like ray tracing or DLSS (if supported) and see if they’re active in Spore. While Spore is an older game, modern drivers often optimize performance for legacy titles, so even subtle changes can indicate a successful update.
A common mistake is assuming the update worked without thorough testing. Spend at least 10–15 minutes exploring different stages of the game—Cell, Creature, Tribal, Civilization, and Space—to ensure consistent improvements across all phases. If you’ve adjusted settings like resolution or VSync, test both fast-paced and slow-paced scenarios to evaluate frame rate consistency. For example, fly through a densely populated planet in the Space stage to check for lag or stuttering, which could indicate unresolved issues despite the update.
If the visuals haven’t improved, double-check that the correct graphics card is being utilized. On Windows, open Task Manager (Ctrl+Shift+Esc) while Spore is running to confirm GPU usage under the “Performance” tab. For laptops with dual GPUs, ensure the high-performance card is selected in your graphics settings. If the issue persists, revert to the previous driver version or consult the manufacturer’s support page for compatibility issues.
Finally, consider community feedback or forums for troubleshooting tips specific to Spore. Some users report better results with older driver versions or third-party mods that enhance graphics. If the update has worked, take note of the changes and document them for future reference. This not only confirms the success of your efforts but also provides a baseline for future optimizations. Restarting Spore isn’t just a formality—it’s the critical step that bridges technical adjustments with tangible, in-game results.
Can Dawn Dish Soap Effectively Eliminate Mold Spores in Your Home?
You may want to see also

Troubleshoot Issues: Resolve common problems like crashes or glitches post-update with quick fixes
Updating your graphics card drivers can breathe new life into *Spore*, enhancing visuals and performance. However, post-update crashes or glitches can be frustrating. These issues often stem from compatibility conflicts, outdated DirectX versions, or residual files from previous installations. Before diving into troubleshooting, ensure your system meets *Spore*’s minimum requirements: a 2.0 GHz CPU, 512 MB RAM (1 GB for Windows Vista/7), and a 128 MB graphics card supporting Pixel Shader 2.0. If your hardware checks out, proceed with these targeted fixes.
Step 1: Verify Driver Compatibility
Not all drivers play nicely with *Spore*, especially newer ones optimized for modern games. If crashes occur post-update, revert to a previous driver version known to work with *Spore*. NVIDIA and AMD both offer archives of older drivers on their websites. Download the version corresponding to your card and operating system, uninstall the current driver using Display Driver Uninstaller (DDU) in safe mode, and install the older one. This often resolves instability caused by incompatible optimizations.
Step 2: Update DirectX and .NET Framework
Spore relies heavily on DirectX 9.0c and .NET Framework 3.5. Missing or corrupted files in these frameworks can trigger glitches or crashes. Download the latest DirectX End-User Runtimes from Microsoft’s official site and reinstall .NET Framework 3.5 via Windows Features (Control Panel > Programs > Turn Windows features on or off). Restart your system after installation to ensure changes take effect.
Step 3: Clear Shader Cache and Game Files
Corrupted shader cache or game files can cause graphical anomalies. Navigate to *C:\Users\[YourUsername]\AppData\Local\SPORE* and delete the *ShaderCache* folder. Additionally, verify the integrity of *Spore*’s game files via Origin or Steam (right-click the game > Properties > Local Files > Verify Integrity). This replaces missing or damaged files without requiring a full reinstallation.
Step 4: Adjust In-Game Settings and Compatibility Mode
Sometimes, the simplest fixes are the most effective. Lower in-game graphics settings like resolution, anti-aliasing, and shadow quality to reduce strain on your GPU. If crashes persist, run *Spore* in compatibility mode for Windows XP SP2 or SP3. Right-click the game’s executable, select Properties > Compatibility, and apply the settings. This workaround bypasses conflicts with newer operating systems.
Caution: Avoid Overclocking and Mod Conflicts
While overclocking can boost performance, it increases the risk of crashes and glitches. Revert your GPU and CPU to stock speeds temporarily to isolate the issue. Similarly, disable *Spore* mods or custom content, as they may not be compatible with updated drivers or game versions. Reintroduce them one by one to identify the culprit.
By systematically addressing these common issues, you can restore *Spore*’s stability and enjoy its unique gameplay without interruptions. Patience and methodical troubleshooting are key—each fix brings you closer to a seamless experience.
Mastering Spore's Creature Stage: Crafting an Epic Beast Step-by-Step
You may want to see also
Frequently asked questions
Visit your graphics card manufacturer’s website (NVIDIA, AMD, or Intel), download the latest driver for your specific card model, and install it following the on-screen instructions.
Yes, Windows Update can sometimes provide driver updates, but for the latest version, it’s best to download directly from the manufacturer’s website.
Try rolling back to the previous driver version or reinstall the latest driver after a clean uninstall using Display Driver Uninstaller (DDU).
Check for updates every 3-6 months or when you encounter performance issues, as newer drivers often include optimizations and bug fixes.